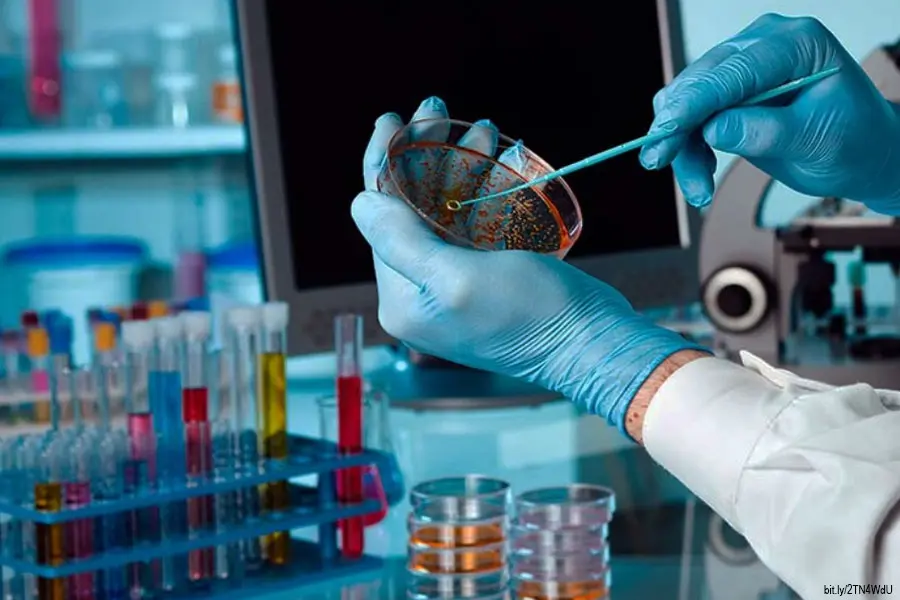

Desarrollan una nueva molécula para el tratamiento dirigido contra el cáncer
El receptor diana al que se une la nueva molécula desempeña un papel muy importante en la agresividad de los tumores
Actualizado: 23 de Julio, 2025, 12:08 PM
Publicado: 30 de Mayo, 2023, 09:46 AM
Barcelona /España).– Barcelona /España).- Un equipo de investigadores del Instituto de Investigaciones Biomédicas de Bellvitge (Idibell) y la Universidad de Iowa desarrolló una nueva molécula capaz de reconocer con gran precisión las células tumorales.
En concreto, se trata de un nuevo aptámero, un tipo de molécula de ácidos nucleicos que adopta estructuras tridimensionales y es capaz de reconocer específicamente moléculas diana.
Esta nueva molécula, presentada en la revista científica Molecular Therapy-Nucleic Acids, podría utilizarse de plataforma para liberar tratamientos contra el cáncer de forma localizada y reducir efectos secundarios no deseados, ha explicado este martes el Idibell en un comunicado.
La molécula desarrollada reconoce al receptor EphA2, altamente expresado en multitud de cánceres como los sarcomas, el cáncer de mama, el melanoma o el cáncer colorrectal, entre otros, y que, en cambio, está muy poco expresado en las células sanas, lo que le convierte en un candidato ideal como diana de la terapia dirigida.
"Los aptámeros, a diferencia de los anticuerpos u otras plataformas de liberación localizada de fármacos, se pueden unir a cualquier tipo de terapia, sea quimioterapia o tratamientos con ARN contra el cáncer. Además, pueden producirse a gran escala y sin variabilidad entre lotes", señaló el jefe del grupo de investigación en Sarcomas del Idibell y uno de los líderes del proyecto, Òscar Martínez.
Además, aparte de actuar como una plataforma dirigida de liberación de fármacos, el equipo investigador comprobó que el aptámero por sí solo ya tenía efecto antitumoral.
El receptor diana al que se une la nueva molécula desempeña un papel muy importante en la agresividad de los tumores, y los investigadores observaron que la misma unión del aptámero reducía la capacidad metastásica de las células en cultivo.
"Podríamos decir que el aptámero solo ya tiene un efecto preventivo, ralentiza la evolución del cáncer. El solo podría ayudarnos a convertir el cáncer en una enfermedad crónica, y a la vez, conjugado con fármacos contra el cáncer, podría ser aún más potente", añadió Martínez.

Agencia EFE
La Agencia EFE, o simplemente EFE, es una agencia de noticias internacional con sede en Madrid. Fue fundada en 1939 gracias al impulso del entonces ministro del Interior, Ramón Serrano Suñer, en la que participaron activamente: José Antonio Jiménez Arnau, Manuel Aznar Zubigaray y Vicente Gállego.
Biografía completa »